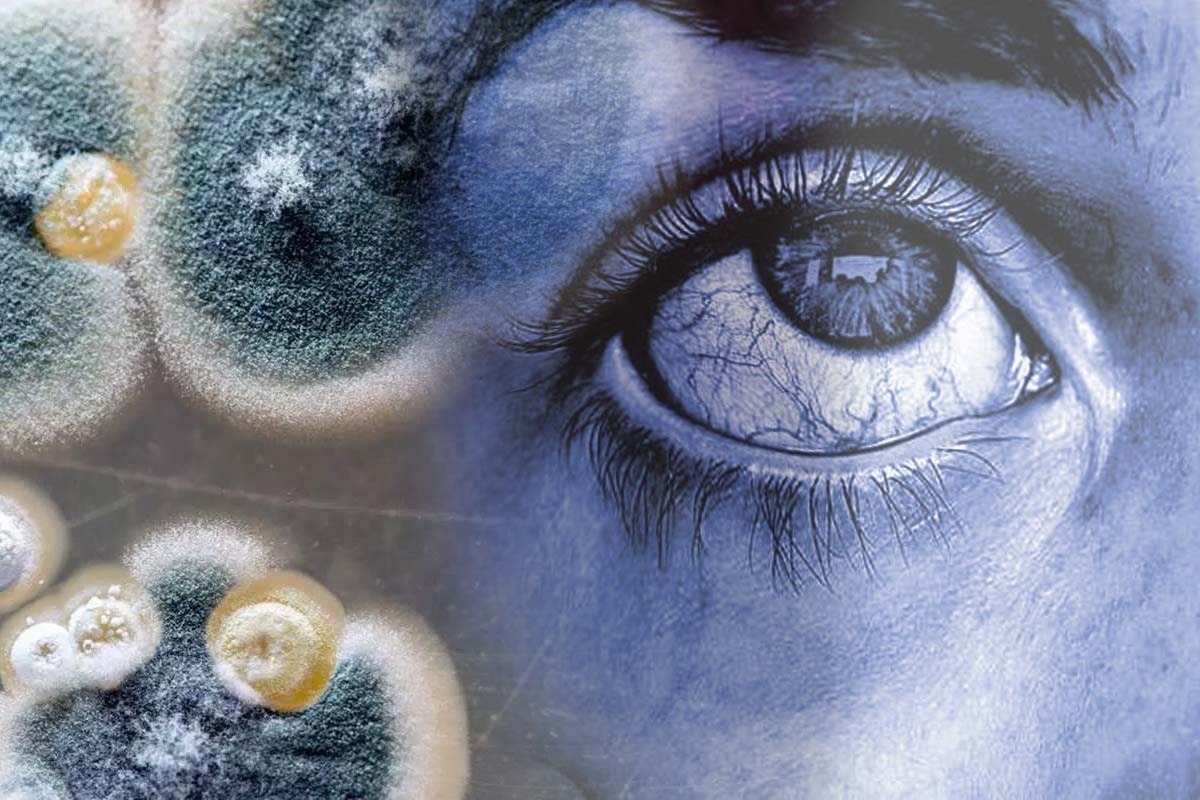
Morre paciente com suspeita de ‘fungo preto’ no Mato Grosso do Sul

Morreu na tarde desta quarta-feira (3) o paciente com suspeito de ser portador de mucormicose, conhecido popularmente como, ‘fungo preto’, identificado em Mato Grosso do Sul.
De acordo com o Estadão, os sintomas do fungo preto apareceram em 28 de maio, quando o paciente apresentou inchaço e lesão com necrose nas pálpebras, além de hemorragia no olho esquerdo.
O paciente de 71 anos tinha recebido as duas doses da vacina contra covid entre março e abril deste ano.
A mucormicose ganhou destaque nos últimos dias pelo registro de mais de 9 mil casos na Índia, que têm sido associados ao novo coronavírus no país asiático.

Aviso